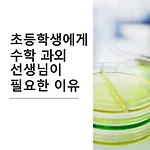

목록초등학교 수학 (27)
생활 과학 넘버원
 수학강사 선택 방법
수학강사 선택 방법
좋은 수학 강사 선택 방법 1. 강사의 강의 스타일 파악 ● 강의 방식: 강의 중심, 토론 중심, 문제 풀이 중심 등 선호하는 방식 확인 ● 설명 방식: 명확하고 이해하기 쉬운지, 다양한 예시 활용, 개념 설명 방식 확인 ● 강의 분위기: 흥미 유발, 적극적인 참여 유도, 질문 환영 여부 확인 2. 강사의 경력 및 역량 평가 ● 수학 전문성: 관련 학과 졸업, 수학 교육 경험, 전문 지식 보유 여부 확인 ● 강사 경력: 강의 경력, 다양한 학생 유형 대상 경험, 성공 사례 확인 ● 교육 방법: 맞춤형 교육, 학습 흥미 유발, 학습 성취도 향상 노력 확인 3. 학생과의 상성 고려 ● 강사 성격: 학생과의 소통 능력, 인내심, 긍정적이고 격려하는 태도 확인 ● 학생 특성: 학습 스타일, 성격, 이해 수준 고..
 [초등 수학] 초등학교 수학 학원? 공부방? 독학?
[초등 수학] 초등학교 수학 학원? 공부방? 독학?
초등 수학 학습 방법은 아이의 학습 성향, 이해도, 목표, 부모의 참여도 등에 따라 다르므로 일률적인 답은 없습니다. 각 방식의 장단점을 비교하여 아이에게 가장 적합한 방법을 선택하는 것이 중요합니다. 1. 학원 장점: ● 체계적인 학습: 전문 강사의 지도를 통해 체계적인 수학 개념과 문제 풀이 방법을 익힐 수 있습니다. ● 다양한 문제 유형 접하기: 교과서 수준을 넘어 다양한 문제 유형을 접하며 사고력을 키울 수 있습니다. ● 즉각적인 피드백: 강사로부터 즉각적인 피드백을 받으며 오류를 바로잡고 개선할 수 있습니다. ● 학습 동기 부여: 친구들과 함께 공부하며 학습 동기를 부여받을 수 있습니다. 단점: ● 비용 부담: 학원 수강료는 경제적 부담이 될 수 있습니다. ● 개인 맞춤 학습 어려움: 다수의 학..
 초등학교 고학년에게 유익한 공부시간은 하루에 몇시간?
초등학교 고학년에게 유익한 공부시간은 하루에 몇시간?
초등학교 고학년 학생들의 적절한 학습 시간은 개인의 학습 수준, 흥미, 집중력, 그리고 주변 환경 등에 따라 다르기 때문에 단정적으로 답변하기 어렵습니다. 하지만, 일반적으로 다음과 같은 시간을 권장합니다. 초등학생에게 적절한 학습 시간 • 학교 수업 시간: 하루 평균 6시간 • 숙제: 하루 평균 30분 ~ 1시간 • 자기주도 학습: 하루 평균 30분 ~ 1시간 총 학습 시간은 하루 평균 7시간 ~ 9시간 정도가 되는 셈입니다. 다만, 일반적인 권장 시간이며, 아이의 상황에 따라 조절해야 합니다. 다음은 학습 시간을 조절하는 데 고려해야 할 몇 가지 요소입니다. • 학습 수준: * 학습 수준이 높은 아이는 더 많은 학습 시간이 필요할 수 있습니다. * 학습 수준이 낮은 아이는 더 적은 학습 시간으로도 충..
초등학생에게 수학 과외 선생님이 필요한 이유
초등학생에게 수학 과외 선생님이 필요한 이유
초등학생에게 수학과외가 필요한지 여부는 여러 가지 요소를 고려해야 하기 때문에 단정적으로 답변하기 어렵습니다. 다음은 수학과외를 고려해야 할 경우를 나타내는 몇 가지 지표입니다. 수학과외가 필요한 사람에 대한 루틴 학교 수업 내용 이해에 어려움을 겪는 경우: 기본 개념을 이해하지 못하거나, 문제를 풀면서 어려움을 느끼는 경우 숙제나 시험에서 낮은 점수를 받는 경우 수학에 대한 흥미나 자신감이 부족한 경우: 수학을 배우는 것이 지루하거나 어렵다고 느끼는 경우 수학에 대한 자신감이 부족하여 적극적으로 참여하지 않는 경우 특정 목표를 달성해야 하는 경우: 수학 경시대회에 참가할 계획인 경우 특정 수준의 학업 성취를 목표로 하는 경우 반면, 다음과 같은 경우에는 수학과외 없이도 충분히 학습할 수 있습니다. 학교..
